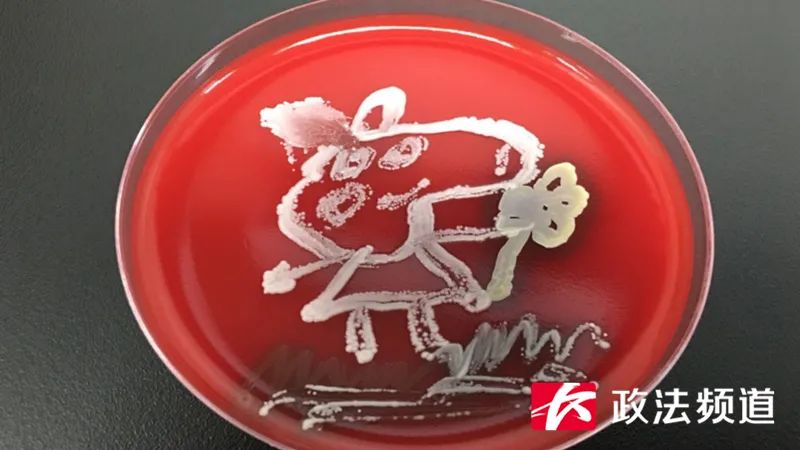
脑洞大开！用细菌作画你见过吗？长沙90后医生做到了

最近,一段培养皿里
“长”出小猪佩奇的视频
在网络上走红
不少人都好奇
这个小猪佩奇是如何“变”出来的
记者今天从湖南妇女儿童医院了解到
这是该院检验科的医生在工作之余
用培养皿将细菌绘制成各种卡通图案
为的就是让孩子
更加直观感受细菌的存在

“像小猪佩奇的那个棒子,我们用的金黄色葡萄球菌摊在血平板上,经过一定的溶血产生的一个效果。而且金黄色葡萄球菌的话,它在血平板上,它还能产生一个黄色的色素,就是这样所呈现出来的。还有就是表皮肤球菌,它整个就是一个白色的一个菌落,所以我们用这两个菌落组合起来的一个图案,我们培养了四十八个小时。”湖南妇女儿童医院检验科微生物实验室负责人杨宇介绍,这个奇特的想法是科室的90后医生最初想到的,从作画到培养,总共花了48小时。
儿科在所有医学临床学科当中又被称作“哑科”,因为医生面对的往往是年龄较小的患儿,他们无法清晰表达出自己的不适症状,而这样生动的作画方式,能够很快拉近医生和患儿之间的距离感,从而达到更好的诊疗效果。

“我们今天制作的这些图案,以后我们会把它做成一个小册子,打印出来放在我们的前台,随时可以供我们的家属、小朋友进行观看,进行知识宣讲。让他们知道致病菌离我们其实并不远,所以我们要做好预防。”杨宇介绍,儿科医生们是想通过这种方式,让孩子更重视个人卫生。“其实细菌并不可怕,我们要加强自身的锻炼、自身的抵抗能力,就可以完全打败它们的,我们也可以和细菌共存的。”
记者:骆妍婷 编辑:月光

速来报名!政法频道喊你留在长沙过年,团圆饭、年货免费送到家!
刚刚起程!湘雅医院5名重症医护专家驰援吉林战“疫”(视频)
长沙一银行职员冬夜跳进湘江救下18岁女孩,后续故事更暖心